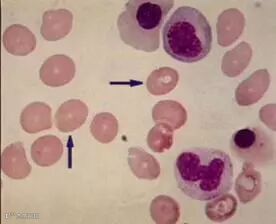

说起叶酸,大家应该不陌生,但是让仔细说说,好像又说不出来多少,它就像一个成天被我们提起,却又知之不多的邻家菇凉。
叶酸,实际上是一种水溶性的维生素,
也被称为:维生素B9、抗贫血因子、蝶酰谷氨酸等

四氢叶酸是一种还原型叶酸,亦称辅酶F,是辅酶形式的叶酸的母体化合物。当叶酸缺乏或某些药物抑制了叶酸还原酶,使叶酸不能转变为四氢叶酸,都可影响血细胞的发育和成熟,造成巨幼红细胞性贫血。
叶酸缺乏对人会有什么影响?
目前有许多文献报道,缺乏叶酸与神经管畸形、巨幼细胞贫血、唇腭裂、抑郁症、肿瘤等疾病有直接关系。一般情况下,正常人的需要量为100~200 ug/d,世界卫生组织的推荐量为:成人200 ug/d,孕妇和乳母400 ug/d。FDA 的最新叶酸食用量标准如下:25 岁~50岁(男性)为240 ug/d;25岁~50岁(女性)为190 ug/d;乳母、孕妇为400 ug/d;婴幼儿为200~400 ug/d。有调查表明,我国处于生育年龄的妇女体内叶酸水平普遍偏低,而对于妊娠期妇女,由于胎儿在母体中的生长发育和胎盘、子宫的长大,对叶酸的需求量又比较大。
体内叶酸水平比较低怎么解决?
最佳的方法是食补。
叶酸广泛分布于绿叶植物中,如菠菜、甜菜、硬花甘蓝等绿叶蔬菜,在动物性食品(肝脏、肾、蛋黄等)、水果(柑橘、猕猴桃等)和酵母中也广泛存在。
具体举例来说,含叶酸的食物有:
1、绿色蔬菜:莴苣、菠菜、西红柿、胡萝卜、青菜、龙须菜、花椰菜、油菜、小白菜、扁豆、豆荚、蘑菇等。
2、新鲜水果:橘子、草莓、樱桃、香蕉、柠檬、桃子、李、杏、杨梅、海棠、酸枣、山楂、石榴、葡萄、猕猴桃、梨、胡桃等。
3、动物禽肉及蛋类,如猪肝、鸡肉、牛肉、羊肉等。
4、豆类、坚果类食品黄豆、豆制品、核桃、腰果、栗子、杏仁、松子等。
5、谷物类大麦、米糠、小麦胚芽、糙米等。
6、核桃油里也含有叶酸。
通常来说,一般成年人只要在膳食搭配合理、烹饪方法得当的情况下,是不会存在叶酸缺乏问题的。
人体自身无法合成叶酸,只有从外界饮食中获取
哪些人需要特别注意叶酸的补充?
处于孕产期的准妈妈。由于怀孕所需叶酸较未孕时高出好几倍,孕期血清和红细胞叶酸含量也会随着妊娠进程而逐渐降低,所以孕期需要注意叶酸的补充。
处于哺乳期的婴幼儿,如果妈妈自身饮食习惯等方面的原因,造成母乳中的叶酸含量不足,也需要注意对婴幼儿体内叶酸的补充。
患有心脑血管疾病的老年人,如果体内叶酸缺乏,也可能会诱发心血管疾病的发作,因此,老年人适当补充叶酸,能在一定程度上起到预防作用。
长期大量服用维生素C的人。维生素C可抑制肠道对叶酸的吸收,会加速叶酸的排出,所以经常服用维生素C的人必须在停止服用维生素C的间歇期增加叶酸。

叶酸补充的越多越好吗?
非也!过度的补充叶酸反而会干扰孕妈妈的锌代谢,锌一旦摄入不足,反而会影响胎儿的发育 。 所以,任何事物都有它的正负两面性,在合理适度的范围内补充就是好的一面,一旦过量就会展现出它的副作用了。

今日推荐
维爱佳妈妈孕期奶粉

这款孕妇奶粉是根据世界卫生组织和澳洲相关妇幼保健机构的建议而特别研发的能够满足孕期营养需求的孕妇配方奶粉,它科学配比了乳铁蛋白、叶酸、DHA等营养成分和各种人体所需的微量元素。其中叶酸含量达到了272微克/100克,每天饮用可在一定程度上对体内叶酸含量达到促进作用。
详见维爱佳京东旗舰店
获奖公告:
《暑期余额不足?别焦虑 文末惊喜等着你》一文活动获奖名单:
微信昵称为:
A-Queen、木槿七七、悦儿、开心、蜜宝儿
这五位“佳”粉的文末留言点赞数高居前五名,因此荣获维爱佳秋日暖心神秘大礼包一份。特此公告!

VIPLUS DAIRY
百年乳企 为爱而生